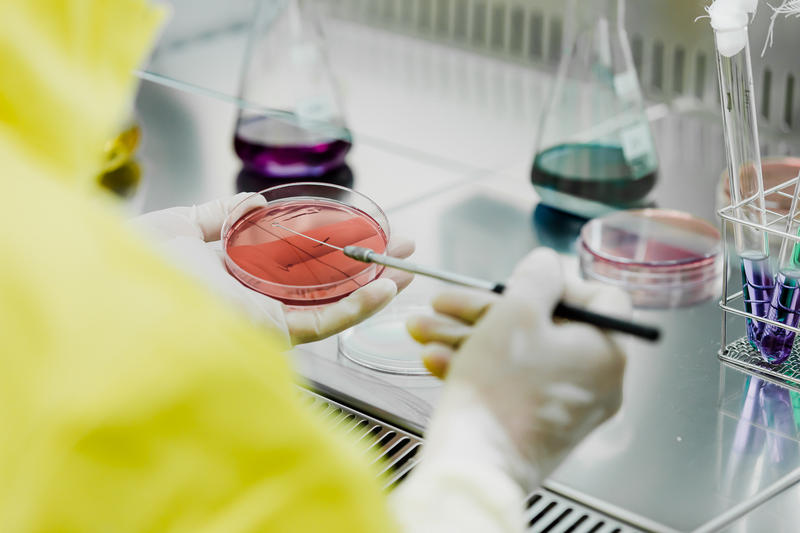
Biofarm, 100 de ani de istorie, Foto: Biofarm

Biofarm, 100 de ani de istorie în industria farmaceutică din România
Istoria farmaceutică modernă datează de la mijlocul anilor 1800, când farmaciile își extind serviciile de distribuție de medicamente din plante la dezvoltarea primelor substanțe chimice. La începutul secolului 20, industria farmaceutică se dezvoltă la nivel mondial și România face primii pași în cercetare prin intermediul unor întreprinderi mici.
Pentru a ține pasul cu evoluția rapidă din industria farmaceutică, acestea fuzionează și 1921 devine anul fondator pentru Biofarm. Rezultatele fuzionării micilor întreprinderi nu întârzie să apară, produsele Biofarm având o contribuție majoră la creșterea calității vieții în rândul pacienților români din anii `20. Printre aceste produse se numără si Carmol, lansat în 1928, fiind astfel cel mai longeviv și unul dintre cele mai cunoscute produse ale companiei.
Inovația, motorul companiei
Au trecut mai bine de 90 de ani de la lansarea Carmol și 100 de ani de activitate continuă pentru compania cu sediul central în strada Logofătul Tăutu. 100 de ani în care misiunea Biofarm de a face bine s-a concretizat prin fiecare acțiune a companiei. 100 de ani de ani în care grija și responsabilitatea față de clienți au fost primordiale. 100 de ani de inovații constante. 100 de ani în care Biofarm a lansat sute de produse în peste 60 de arii terapeutice, multe dintre acestea și astăzi lideri în categoriile lor.
Printre acestea se numără și Triferment, Anghirol, Colebil sau Cavit, dovadă incontestabilă a calității extraordinare a produselor, dar și a faptului că pasiunea pentru a identifica cele mai bune soluții de tratament a fost întotdeauna una dintre valorile de baza a intregii echipe de cercetare-dezvoltare Biofarm.
Inovația constantă și diversitatea portofoliului au diferențiat întotdeauna Biofarm de competitori și au adus companiei rezultate remarcabile de-a lungul timpului și au contribuit semnificativ la evoluția companiei în cei 100 de ani de activitate. Actualizarea continuă a portofoliului de bază Biofarm, cât și lansarea de noi produse în categoriile cele mai efervescente din industrie au diferențiat întotdeauna Biofarm în contextul competitiv al pieței farmaceutice din România ultimilor 20 de ani.
Mixul dintre brandurile longevive și inovațiile din categoriile emergente ale industriei plasează astăzi Biofarm în topul companiilor din categoria Consumer Healthcare și în poziția de lider incontestabil pe piețele de digestie, biliare, decongestionante nazale, antireumatice topice, insuficiență venoasă, anxiolitice și hipnotice.
Dezvoltările de produse recente din portofoliul Biofarm ocupă poziții importante în segmentele de piață în care acestea activează, cum ar fi laxative, hepatice, balonare și antiflatulență, vitamine pentru copii sau durere în gât.

Investiții constante în viitor
Povestea companiei nu este doar despre portofoliul extins de produse, ci și despre responsabilitatea față de generații întregi de consumatori, ceea ce a determinat Biofarm să privească întotdeauna spre viitor înainte de orice acțiune și decizie de business.
Centenarul aduce în prim plan cea mai importantă investiție a ultimilor 30 de ani în industria farmaceutică locală – o unitate de producție construită de la zero, cu instalații și utilaje moderne, condusă de o echipă de specialiști în continuă formare.
Dedicată misiunii de a face bine prin perfecționare continuă, echipa Biofarm lucrează permanent pentru a păstra performanța și inovația la cel mai înalt nivel. Își pune zilnic cunoștințele și expertiza în slujba binelui, în noile laboratoare dotate cu echipamente de ultimă generație.
Cu o suprafață utilă de peste 7.000 mp și un flux de producție anual de peste 30 milioane de unitati comerciale de comprimate și capsule și peste 10 milioane de produse în formă lichidă, noua fabrică Biofarm contribuie major la creșterea producției și va face posibilă extinderea pe noi piețe.
Dorința autentică de a face bine a fost motorul care a ținut viu business-ul Biofarm timp de 100 ani și reprezintă premisa urmatoarei ere de inovație și performanță Biofarm în industria farmaceutică.
Articol susținut de Biofarm
 INTERVIURILE HotNews.ro
INTERVIURILE HotNews.ro































